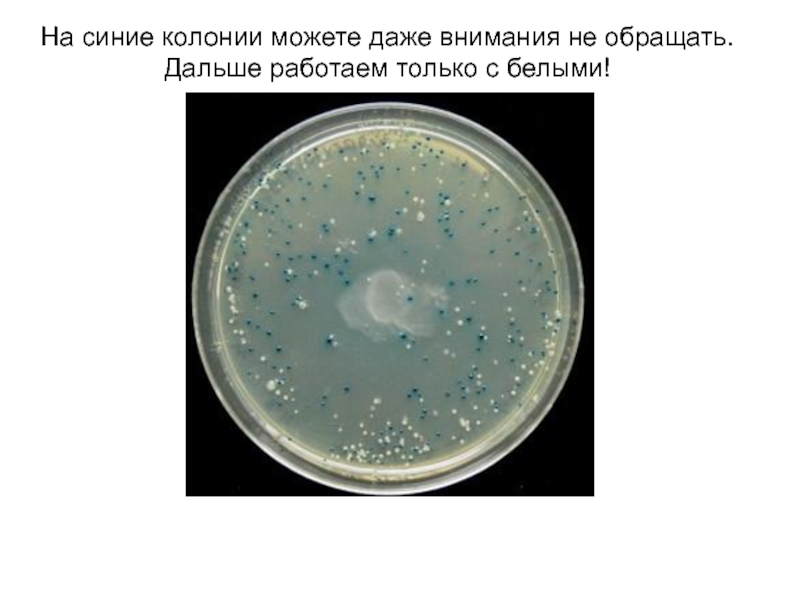

сильнее в очищении Na, тем он мощнее в приеме солнечной
энергии. Взаимодействие Na-основы и Na’, будет давать Na’’. Т.е. система объединений энергий – это очищение. Изначальный Na уже не существует, он провзаимодействовал с Na’ и все его действия при этом закончились. Был Na-изначальный, добавили Na-жженый = Na’ – клон №1. К Na’ добавили Naж’ = Na’’. Следующий клон – Na’’ сжигается, получается Na’’ + Na’’жженый = патрица. Na-патрица + Na-патрица(жженый) = Na-матрица Патрица – это клон в действии. Т.е. первоосновный Na не дает Матрицу и Патрицу, их дает процесс последовательного клонирования.Леонтьева А.И., «Здоровье человека – это состав его крови». Журнал «Успехи современного естествознания», 2010, №12, стр. 85-88.
Клонирование – это из 10 мл, взятой из вены крови – 3 мл выпиваются, 7 мл переводятся в пепельную структуру в печах при температуре 600 0С, и принимают во внутрь в капсулах.
При клонировании идет пересоздание элементов – это тот же элемент, но уже «качественней». Был изначально Na, после клонирования стал Na-полиэстер, т.е. Na с другой энергией, т.е. при клонировании идет процесс, способный давать «великое из простого». В центре Na тот, что был изначально. В клоне он имеет более высокую энергию «Na’». «Na’» – это натрий полученный за счет насыщения энергий изначального Na, являющегося основой.